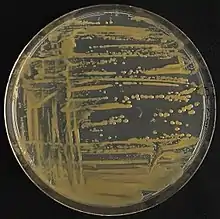

Xanthomonas campestris
Predominantemente com geração isolada, a bactéria Xanthomonas campestris e suas variações recebem a denominação de gram-negativas e possuem morfologia semelhante a bastonetes.[1]
Utilização
Este tipo de bactéria, junto as suas diferentes espécies, possuem a capacidade de confeccionar através de fermentação o polissacarídeo Goma Xantana quando introduzido em meio contendo fontes de carbono, nitrogênio, fósforo junto a outros micronutrientes, possuindo um grande valor agregado visto as suas características reológicas. Pode ser maximizado com um consequente meio fermentativo com dosagens específicas de nutrientes e o respectivo controle de parâmetros como temperatura, pH, pressão, entre outros, que promovem melhor adaptação da variedade do microrganismo no meio selecionado.[2]
Referências
- Garcı́a-Ochoa, F; Santos, V.E; Casas, J.A; Gómez, E (novembro de 2000). «Xanthan gum: production, recovery, and properties». Biotechnology Advances. 18 (7): 549–579. ISSN 0734-9750. doi:10.1016/s0734-9750(00)00050-1
- Brandão, Líllian Vasconcellos; Nery, Tatiana Barreto Rocha; Machado, Bruna Aparecida Souza; Esperidião, Maria Cecília Azevedo; Druzian, Janice Izabel (dezembro de 2008). «Produção de goma xantana obtida a partir do caldo de cana». Ciência e Tecnologia de Alimentos. 28: 217–222. ISSN 0101-2061. doi:10.1590/s0101-20612008000500033